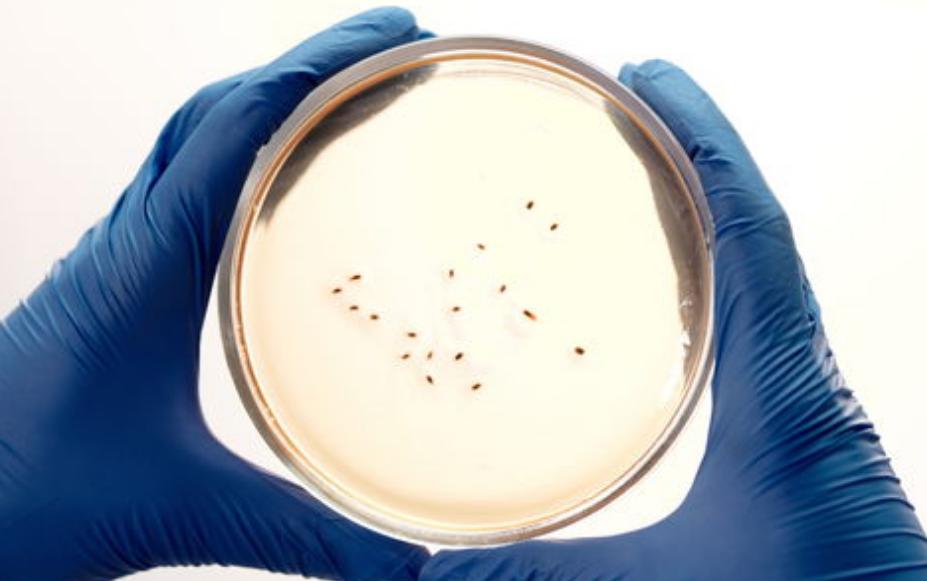
人体润滑剂，对男性伤害大还是女性？能长期用吗？为了健康早了解

林女士今年55岁,已经绝经3年了,她和老公是通过自由恋爱而相识,并且还是彼此的初恋,经过5年的相处最终步入了婚姻殿堂,所以两人感情一直都很好,年龄增长也完全没有影响到两人正常的夫妻生活。
直到最近,每一次夫妻生活时她都感觉自己 下面异常的干涩、疼痛 ,为了不影响夫妻感情,她也没有跟老公提过这件事情,但是她对夫妻生活的异常排斥还是让其老公察觉出来了异常。

之后,两人针对这一件事情进行了沟通,最终决定之后可以用点润滑剂,但是两人又担心润滑剂会对身体有害,便去到了医院咨询。
一、润滑剂的种类有这么多?快看看你了解吗!
目前在售的润滑剂有很多种,很多人在选择时会特别的迷茫,那么,润滑剂都有哪几种呢?
目前市面上比较常见的润滑剂主要有三种: 水基润滑剂、油基润滑剂以及硅基润滑剂。因为主要成分不同,所以适用于不同的人群。
作为目前最常见的一种润滑剂,水基润滑剂的主要成分是水、甘油和纤维素*醚乙**等,外观看起来比较像水,而且在使用时也不会有油腻感,因此被广泛使用。

但是很多人在使用的过程中会面临一个问题,那就是挥发的比较快。这对润滑剂的使用性能影响还是比较大的,因为润滑剂除了对润滑效果要求比较高之外,第二个要求就是要够持久,因此还有可以提升的空间。
相比于水基润滑剂, 油基润滑剂 的使用量就比较少了,该润滑剂从外表看起来就会让人有一种不想用的感觉,这主要是因为它是由凡士林一类的油类产品所组成的,外表十分油腻,使用起来也是如此。
此外,它还有一个缺点那就是比较难洗净,其实这也不难理解,因为它是由油类成分所组成的。这也从侧面反映出,它有较长的持续时间,因为油类材质较难挥发。

除了上面两种润滑剂还有硅基润滑剂,是一种人们可能叫不上来名字,但是却很熟悉它的用途的一种润滑剂。为什么这么说呢?
因为它常被使用在避孕套上,也是避孕套的主要成分。它是由有机硅所构成,该成分不溶于水,因此 清洗起来比较麻烦 ,这也算是它的一个小缺点。不过无伤大雅,因为它不会对安全套的质量造成影响。
因此在选择的时候,首先要根据不同润滑剂的成分和原理,进行合理的选择。在使用润滑剂时,注意避免相似相溶(比如:油基润滑剂会造成避孕套溶解)和过敏,一般情况下是没有什么禁忌症的。而且有规律地使用水性人体润滑剂一般是不会对人体造成伤害的。
但是,长期使用润滑剂真的对人体无害吗?如果长期使用又会给人体带来哪些损伤呢?

二、同房时长期用润滑剂真的好吗? 对身体有伤害没?
随着年龄的不断增长,女性体内的雌激素分泌会不断减少,卵巢和子宫功能也会逐渐衰退,阴道分泌物随之减少,阴道就会变得干涩,这对同房时的感受影响是非常大的。
人体润滑剂通过对女性阴道的润滑作用,起到避免因为摩操过大而导致的阴道干涩、疼痛的问题,同时可以在女性的阴道黏膜表面形成一层保护膜,在减少摩擦的同时,起到润滑的作用,提高*生活性**的感受。
但是频繁、长期的使用润滑剂对身体真的好吗?

事实上,正规厂家的润滑剂通常是不会对人体的安全造成影响的,但是仍然有可能会 因为润滑剂不干净、过了保质期、润滑剂没有清洗干净或者是对润滑剂的成分过敏等原因导致润滑剂残留或者细菌感染, 引发阴道或者肛门炎症,得不偿失。
此外, 人体润滑剂对女性的影响是显而易见的 ,这是因为女性的生殖系统比男性的要复杂得多,很可能会因为清洗不够干净彻底,导致润滑剂残留在女性的阴道内;
随着时间的延长以及润滑剂的堆积,残留的润滑液很容易打破女性阴道微生态的平衡,厌氧菌等细菌大量繁殖,引发女性阴道的一些炎症(比如:阴道炎)或者是皮肤感染,严重者还有可能导致宫颈炎等妇科疾病,甚至影响到女性的生育能力。
因此,在使用润滑剂之前一定要检查润滑剂的质量,*生活性**之后一定要清洗干净。
不过,这并不是说使用人体润滑剂对男性就完全没有不良影响,因为如果男性对润滑剂内的某些成分过敏的话,会导致男性*头龟**的皮肤造成一定的刺激,进而导致皮肤干燥、瘙痒。
长期使用的话,还可能会对阴茎表面的皮肤造成损害,从而导致*头龟**软化、感觉减退等问题,严重影响到*生活性**的能力以及感受。
因此,在使用润滑剂之前一定要确认好成分,以防过敏。由此可以看出,使用润滑剂之前,还是有很多事情是需要我们注意的,接下来一起学习一下吧!

三、正确使用润滑剂才能避免伤害,这几点一定要做好!
从上文可以看出,正确的选择和使用人体润滑剂非常重要,这可以减少对身体的伤害,因此在使用时要注意以下几点:
1.选择正规厂家的润滑剂
润滑剂是要涂抹在娇嫩的*处私**皮肤上的,因此对于质量的要求非常高。首先在购买时可以到正规的药店进行购买,以防购买的润滑剂当中含有有害物质;
其次要选择好的牌子, 品质有保证的牌子 ,这种牌子长期制作润滑剂,相关工艺是比较成熟的,润滑剂的成分比较安全,售后服务通常也比较好。因此,在选择润滑剂时,一定要到正规的药店购买,以确保润滑剂的品质。

2.选择适合自己的润滑剂
前文提到润滑剂的种类有很多,因此可以根据产品的特点以及自身的需求进行选择,另外,在购买之前可以在耳后进行皮肤测试,以防对润滑剂的成分过敏,进而导致*处私**瘙痒。
目前很多人会选择使用水基润滑剂,原因是此种润滑剂没有特别的味道,并且清洗起来比较方便。有一点需要提示的是,油基润滑剂和避孕套的成分相似相溶,很容易导致避孕套破裂,因此要避免和避孕套同时使用。
此外,因为润滑剂中的某些化学物质有可能会通过母亲传递给孩子,导致孩子身体损伤,因此, 孕妇、哺乳期女性是禁止使用润滑剂的。
所以,在选择润滑剂时,要根据它的产品性能进行选择,以发挥更好的润滑效果;而且,如果是润滑剂禁忌人群的话,一定要避免使用!

3.注意润滑剂的使用方法
有些人认为润滑剂涂抹的越多越好,但事实上并非这样, 一般情况下涂抹在性接触部位的外侧(均匀地涂抹在阴道口和阴茎表面)就可以了 ,一定要避免用力往里面抹,这很容易导致润滑剂堆积,进而导致*处私**感染;
如果在同房的过程中需要补涂润滑剂的话,一定要先暂停,然后重新进行涂抹。
另外,在房事结束之后一定要及时将润滑剂清洗干净,以防润滑剂在*处私**积聚引发炎症或者感染;如果是比较难以清理的油基润滑剂的话,可以选择使用香皂皂进行清洗,但是一定要注意用量以及力度以防对*处私**造成损伤。
此外, 要注意不能过于频繁,因为碱性皂液会影响女性阴道的酸碱度,导致阴道炎等妇科炎症。

4.注意润滑剂的保存方式
前文提到,很多润滑剂对人体造成损害就是因为其中含有其他杂质,如果不注意保存方式的话很容易导致润滑剂被污染,进而引发*处私**瘙痒等问题。
因此,润滑剂要 保存在室温、远离阳光直射的干燥通风处 ,以避免因为阳光直射或者空气潮湿导致润滑剂变质;另外,润滑剂 打开之后要尽快使用 ,避免长时间暴露在空气中,被其它物质所污染,增加感染的风险。
因此,使用润滑剂时要格外小心、谨慎,那么,为什么有的人用完之后下面火辣辣的疼呢?
四、用完润滑剂,下面火辣辣的疼是怎么回事?
人们在同房时使用润滑剂是为了减少不适,但是有些人在使用润滑剂之后反倒会加重不适,这到底是怎么一回事呢?

目前,的确有一些 润滑剂添加了独特的热感因子 (比如:辣椒素、芥子油),人们在使用的过程中会感受到火辣辣的感觉,这可以在一定程度上增加同房的快感,但是这种润滑剂并不是每一个人都可以接受的,在使用之前一定要做好心理准备。
不过,如果确定自己购买的不是热感润滑剂那就要注意润滑剂的使用期限、是否合格以及是否是对润滑剂的成分过敏了,这些因素都有可能对皮肤造成刺激,进而引发刺痛、瘙痒。

总结:
女性绝经之后,雌激素分泌会减少,同房时阴道分泌物也会减少,因此会存在阴道干涩的情况,严重的还会出现疼痛,为了改善这一症状,很多人会选择使用润滑剂。但是,在选择润滑剂的时候一定要注意厂家、有效期以及成分,选择适合自己的润滑剂,以免引发不良后果。
参考文献:
[1]梁奕福, 一种医用人体润滑剂及其制备方法. 广西壮族自治区,广西信业生物技术有限公司,2018-06-01.
[2]周晓波.新型阴道润滑剂——酸缓冲热敏凝胶润滑剂获生产上市许可[J].中国计划生育学杂志,2012,20(02):102.
[3]露西,潘铭,小风.妇科手术后,不妨试试人体润滑剂[J].食品与药品,2011,13(08):85.